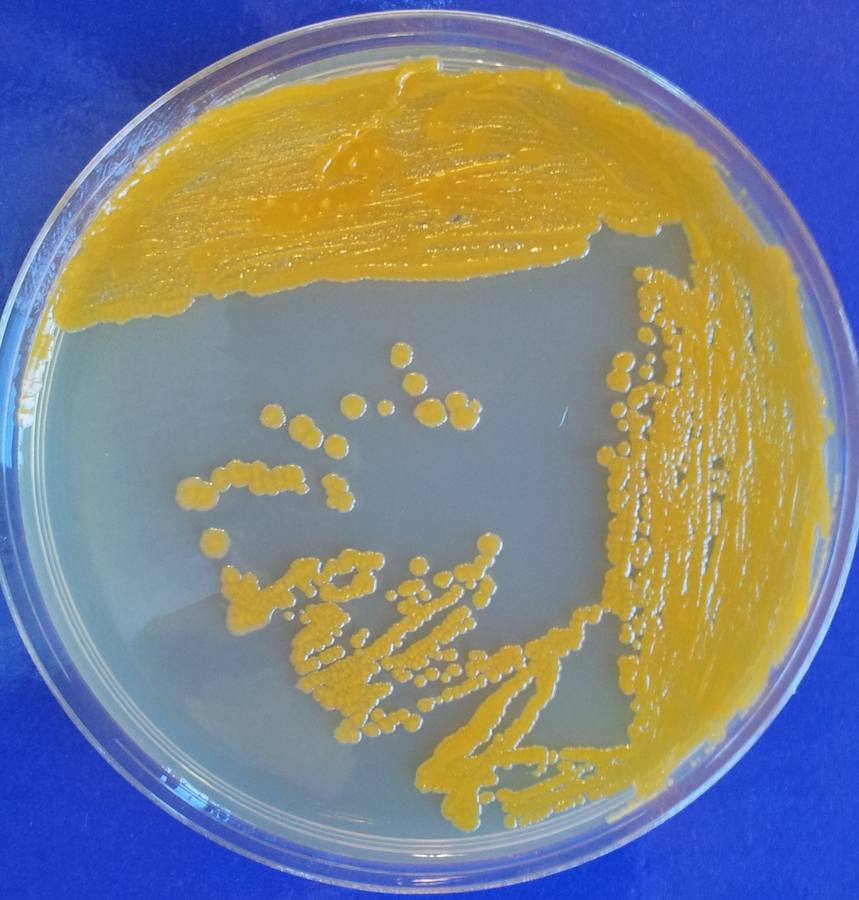
Colonias de la bacteria Mycobacterium neoaurum NRRL B-3805, con su color dorado, de ahí el 'neoaurum' del nombre

El genoma muestra sus cartas
El Inbiotec y Gadea Biopharma publican el genoma de Mycobacterium neoarurum, una microbacteria de crecimiento rápido que permite obtener esteroides de aplicación farmacéutica "a la carta"
nacho barrio
Jueves, 12 de mayo 2016, 17:09
Desvelar el genoma humano ha sido y es la búsqueda del grial científico de las últimas décadas. Una empresa que ofrece el mapa del tesoro repartido en millones de piezas que, a pesar de irse uniendo, aún no permite descubrir el baul lleno de oro. El genoma juega sus cartas, pero empieza a dejar ver sus jugadas.
El Inbiotec leonés junto a la empresa Gadea Biopharma inciaron hace dos años un proyecto tan ambicioso como ilusionante. Una investigación conjunta con la que mejorar la producción esteroides con fines clínicos. El proyecto, llamado 'MySterI', ya ha empezado a mostrar sus primeros logros, siendo el primero haber logrado desentrañar la secuencia del genoma del Mycobacterium neoarum NRRL B-3805, una microbracteria no patógena de recimiento rápido. Las ventajas de este hallazgo son fundamentales en la creación de esteroides "a la carta", ya que se supera así el poco conocimiento que se tenía sobre la composición de éstos y se reduce el coste de su obtención en cerca del 20 por ciento. El genoma consta de 5.065 genes de los cuales un gran número tienen función desconocida, pero sobre los que ahora se investiga.
"Con estos trabajos seguimos siendo punta de lanza" aseguraba Rafael Balaña, director Científico de Inbiotec. Confirmaba sus palabras José Luis Barredo, director de Biotecnología de Gadea Grupo Farmacéutico, que añadía que "este proyecto es como tener un niño, que vas viendo sus pasos y te sientes orgulloso de sus logros como si fueran tuyos".
El proceso es el siguiente. Consiste en realizar la bioconversión de fitosteroles, un residuo de la elaboración del aceite de soja químicamente similar al colesterol. Mediante este proceso, se obtienen precursores esteroideos como androstenediona o el esteroide comercial por todos conocido, la testosterona.
Los esteroides son sin duda una empresa de futuro. Empleados en muchas ocasiones para mejorar los resultados del ejercicio físico, también son clave en la industria farmacéutica en tratamientos preventivos (antitumorales, antiinflamatorios e incluso en el tratamiento del VIH); así como en la regulación de la fertilidad, la menopausia y la osteoporosis. No es una cuestión banal tampoco en lo económico, ya que esta industria mueve entre 7.000 y 8.00 millones de euros.
Este es sin duda el primero de muchos hallazgos que, lejos de cerrar puertas, abre un sinfín de nuevas investigaciones que ayudarán a buen seguro a conocer mejor los secretos de la vida.